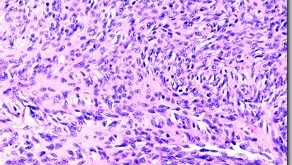

1、免疫组化实验所用的组织和细胞标本有哪些? 实验所用主要为组织标本和细胞标本两大类,前者包括石蜡切片(病理大片和组织芯片)和冰冻切片,后者包括组织印片、细胞爬片和细胞涂片。其中石蜡切片是制作组织标本最常用、最基本的方法,对于组织形态保存好,且能作连续切片,有利于各种染色对照观察;还能长期存档,供回顾性研究;石蜡切片制作过程对组织内抗原暴露有一定的影响,但可 …
阅读更多 »石蜡切片制作(苏木精-伊红对染法)详细步骤
1.取材 颈椎脱臼法处死小鼠,打开腹腔,剪取肝组织(或其他组织)。 切取的组织块不宜太大,以利于固定剂穿透,通常以5mm×5mm×2mm或10 mm×10 mm×2 mm为宜。取下所需要的肝组织,切成一小块2-3mm厚。 注意事项: (1)取材动作要迅速,不宜拖太久,以免组织细胞的成分、结构等发生变化。 (2)切片材料应根据需要观察的部位进行选择,尽可能不要 …
阅读更多 »免疫组化技术大全
一、免疫组织化学简介 免疫组织化学又称免疫细胞化学,是指带显色剂标记的特异性抗体在组织细胞原位通过抗原抗体反应和组织化学的呈色反应,对相应炕原进行定性、定位、定量测定的一项新技术。它把免疫反应的特异性、组织化学的可见性巧妙地结合起来,借助显微镜(包括荧光显微镜、电子显微镜)的显像和放大作用,在细胞、亚细胞水平检测各种抗原物质(如蛋白质、多肽、酶、激素、病原体 …
阅读更多 »如何制作石蜡切片(H.E.对染法)?
一、实验原理: 石蜡切片是最基本的切片技术,冰冻切片和超薄切片等都是在石蜡切片基础上发展起来的。苏木素与伊红对比染色法(简称H.E.对染法)是组织切片最常用的染色方法。这种方法适用范围广泛,对组织细胞的各种成分都可着色,便于全面观察组织构造,而且适用于各种固定液固定的材料,染色后不易褪色可长期保存。经过HE染色,细胞核被苏木素染成蓝紫色,细胞质被伊红染色呈粉 …
阅读更多 »免疫组化实验结果的判定原则和分析标准
免疫组化实验结果的判定和分析,就实验结果而言,免疫组化技术主要涉及抗体实验结果的描述与分析、图片的确定与选取、相关数据的提供。 免疫组化结果的判定原则: ⒈必须同时设对照染色。没有对照染色的免疫组化染色结果是不可信的。 ⒉抗原表达必须在特定部位。如LCA应定位在细胞膜上;CK应定位在细胞浆内;PCNA及p53蛋白应定位在细胞核内;EMA应定位在细胞膜上等等。 …
阅读更多 »石蜡切片的操作要点
组织化学中的组织切片主要有石蜡切片法、冰冻切片法和振动切片法等。石蜡切片法比较节省时间,操作容易,可切极薄的组织片(4 μm 以下,通常为6~10μm 厚的切片),能做连续切片,且组织块可包埋在石蜡中永久保存。但石蜡切片只能用于较小的组织块,不适用于大的组织块。石蜡切片法能改变组织内的化学反应,甚至使可显示的酶和其他物质(如脂类)完全丢失,或使蛋白质变性、酶 …
阅读更多 » 英格恩生物技术博客 生物实验干货分享
英格恩生物技术博客 生物实验干货分享